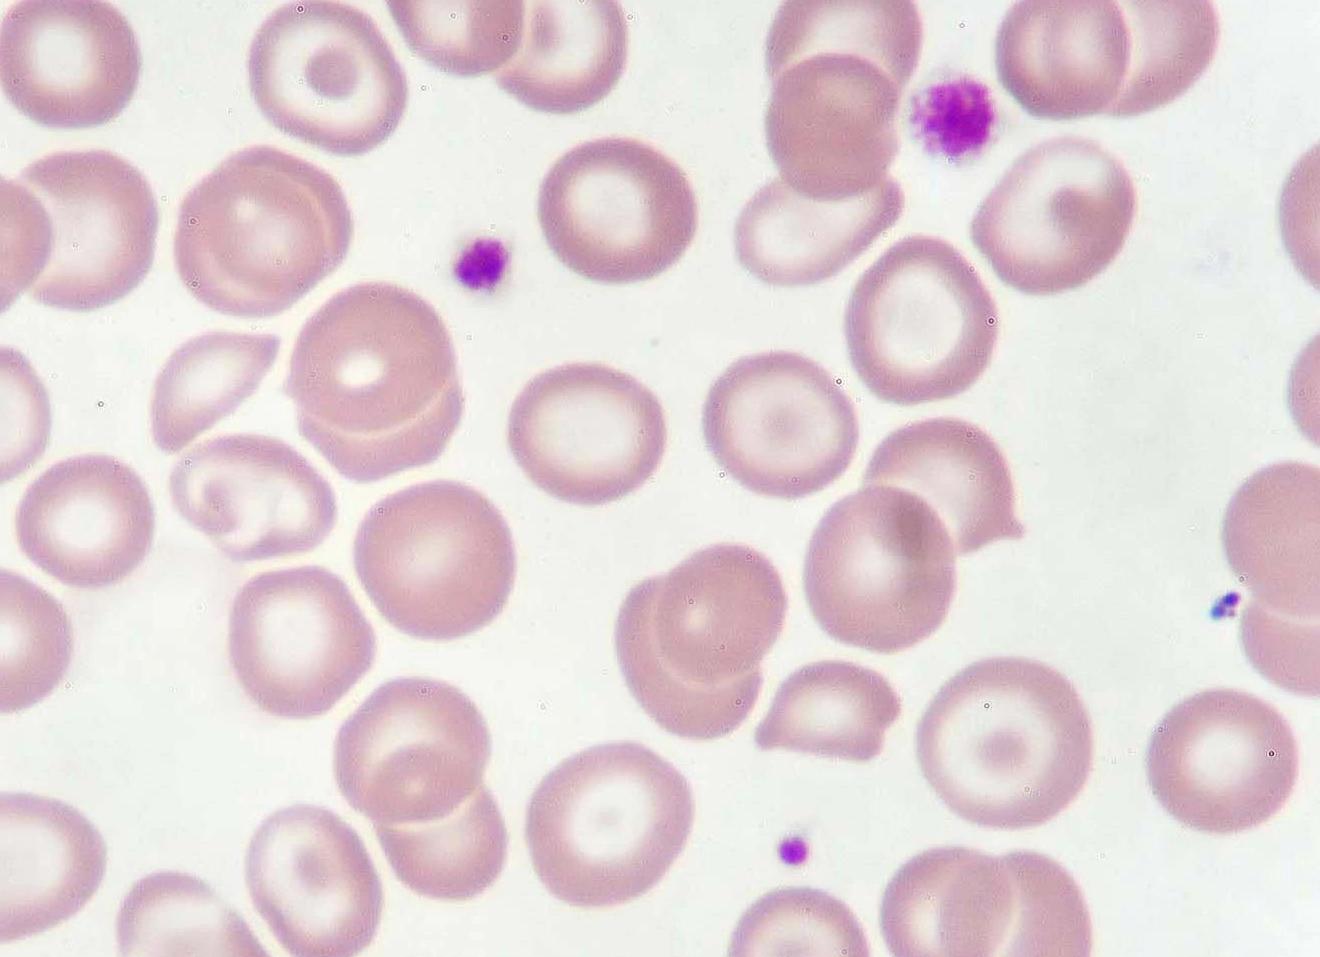
Макроцитарная анемия что это такое

Макроциты в крови Макроцитоз является разновидностью анемии – целой группы синдромов, подразумевающих...
Макроцитарная анемия: причины, симптомы, диагностика, лечение Макроцитарная анемия — это тип анемии,...
Что это такое макроцитарная анемия и как правильно ее лечить В медицине...
Крем макмирор для мужчин инструкция по применению — Про паразитов Многие годы...
Ядерная магнито-резонансная томография – современный метод диагностики Сегодня все чаще пациентов направляют...
Что такое магнитно-резонансная томография МРТ МРТ Организм человека представляет собой тайну, для...
МРТ органов малого таза и тазовой области с контрастом: подготовка и результаты...
Что такое МРТ (магнитно-резонансная томография) Визуальные неинвазивные способы обследования внутренних органов человеческого...
Магнитно-резонансная томография головы Такой вид исследования, как магнитно-резонансная томография мозга, также известная,...
Магнитно резонансная томография головного мозга с контрастированием МРТ головного мозга, в которой...